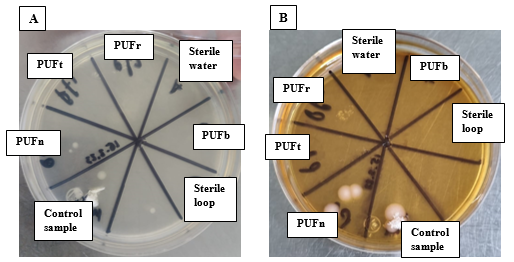

MOJ
eISSN: 2573-2919


Short Communication Volume 9 Issue 4
1Universidad Politécnica Metropolitana de Puebla, Mexico
2Universidad Tecnológica de Izúcar de Matamoros, Mexico
Correspondence: Guillermo Manuel Horta-Valerdi, Universidad Politécnica Metropolitana de Puebla, Universidad Politécnica Metropolitana de Puebla, Popocatépetl s/n Reserva Territorial Atlixcáyotl, Tres Cerritos, CP 72480 Puebla, CP, Mexico Puebla, Puebla, Mexico, Tel +52-2225825222, Ext 104
Received: August 15, 2024 | Published: August 26, 2024
Citation: Horta-Valerdi GM, Crespo-Barrera PM, Navarro-Frómeta AE. Evaluation of the feasibility of reusing polyurethane foam (PUF) cartridges for monitoring bioaerosols. MOJ Eco Environ Sci. 2024;9(4):186-188. DOI: 10.15406/mojes.2024.09.00325
Bioaerosols are a fundamental component of particulate matter present in the air, and numerous sampling and detection techniques have been developed to study them. While the simultaneous determination of organics and microorganisms in particulate matter could offer advantages, this approach has not been well explored. Some techniques for analyzing organic compounds in particulate matter involving using a polyurethane foam (PUF) cartridge or disk which, depending on the analytic procedure, may need to be cleaned with chemicals that could compromise the growth or recovery of microorganisms if used for this purpose. This study aims to determine whether chemical pretreatment of PUF affect negatively the results of the sampling. Additionally, the potential for microorganism growth on previously used PUF was evaluated. After sterilization, the results demonstrated that microorganism growth is possible on both chemically treated and reused PUF. These findings suggest that reusing PUF could reduce costs and waste after sampling.
Keywords: polyurethane foam, reuse, particulate matter, bioaerosol, microorganisms
Particles with different aerodynamic diameters found in the air are a priority pollutant due to their effects on human health.1 A significant part of atmospheric particulate matter are bioaerosols,2–4 which consist of particles of biological origin, including bacteria, fungi, archaea, viruses, pollen, their fragments, components, and by-products, such as DNA, endotoxins, and mycotoxins. Monitoring bioaerosols is crucial for the assessment of air quality, particularly about public health, environmental ecology, and aspects related to atmospheric chemistry. Because bioaerosol concentrations in typical indoor and outdoor environments are relatively low or experience strong temporal fluctuations, there is no bioaerosol sampler that allows the use of a single analytical tool to determine the specific characteristics of the microorganisms present in them, so there is a strong interdependence between the bioaerosol sampling technique and the tools for studying the microbiome present.5,6
Most aerosol sampling devices separate particles from the air stream and collect them in a preselected medium. Gravity-based samplers, impactors, filters, impingers, and cyclones are common sampling techniques used to separate and collect bioaerosols. Electrostatic devices and the lab-on-a-chip platform based on microfluidic technology are also used.7–12
Polyurethane foam (PUF) cartridges and disks are widely used for active and passive sampling of bioaerosols and volatile and semi-volatile organic compounds. In particular, PUFs have been widely used in high-volume active air samplers due to their high retention capacity for organic contaminants. A typical sampling approach involves a pump drawing a known volume of air through a filter to collect particulate-bound compounds. To capture the total concentration of airborne contaminants, a sorbent is added downstream of the filter, and a common extraction and chemical analysis for the filter and sorbent can be applied.13–16 In this way, they can be analyzed with organic contaminants and microorganisms present in the air.17,18
Although the methods that use active sampling with filters and PUF for the determination of organic contaminants indicate that it is possible to reuse polyurethane cartridges, this is not indicated for the case where they are used to determine the biological material present in aerosols. It is therefore novel to evaluate the possibility of reusing polyurethane materials for the microbiological analysis of bioaerosols. Taking this into account, the objective of this work is to evaluate the possibility of reusing PUF cartridges in case it is necessary for logistical reasons to do so.
In this work, the USEPA TO-13 A method was considered for the analysis of bioaerosols, widely used and taken as a reference for many analyses of atmospheric particulate matter in indoor and outdoor environments.19–22 A comparison of the polyurethane foam (PUF) was made to determine whether the cleaning treatment and sample extraction, as indicated by the TO-13a EPA method, affect the recovery of microorganisms (m.o.). The comparison was made with an untreated PUF (PUFb), a treated PUF (PUFt) after the cleaning procedure of the method, and a reused PUF (PUFr) which means that it was employed after the cleaning, sampling, and extraction procedure but without another cleaning. With this in mind, the following methodology is proposed:
Initially, PUFb, PUFt, and PUFr were sterilized using moist heat in an autoclave. A fourth PUF was added, designated as new (PUFn) which will be used as a control for microbial growth., as it underwent neither cleaning treatment nor sterilization and was simply taken from the package. A fragment was cut (inoculum) corresponding to one-fourth of each PUF's diameter and approximately one centimeter thick (Figure 1). This entire process was conducted under aseptic conditions.

Figure 1 Fragment of the four PUFs used for the sterility test. The PUFs were new (PUFn), untreated (PUFb), treated (PUFt), and reused (PUFr).
Subsequently, the inoculum was placed on a sterile Petri dish with sterile commercial isotonic saline solution 0.9% (ISS), widely used for growth studies,23 and was gently mixed. This involved placing the Petri dish on a table and rotating by hand it five times clockwise, five times counterclockwise, five times forward and backward, and five times horizontally. After the mixture procedure, a portion of the resulting ISS was then taken for cultivation on a culture medium under aseptic conditions.
Two culture media were used to compare the ISS obtained from PUFn, PUFb, PUFt, and PUFr. The first medium, LB (Luria-Bertani), is easy to use and versatile, allowing for the growth of a wide variety of bacteria.24 The second medium, BHI (Brain Heart Infusion), is a popular enriched medium ideal for the growth of fastidious bacteria.25,26 Both media can support the growth of a broad range of microorganisms, making them useful for obtaining a representative sample of the microbiota present in a given sample.
For the sterility test of the PUF, an inoculum was taken with a bacteriological loop from the SSI in the Petri dish corresponding to each PUF. It was then streaked using the radial quadrant technique on plates containing the different culture media (Figure 2). Two negative sterility controls were used: a sample of non-sterilized common paper and the non-sterilized PUFn. As a positive sterility control, a streak was made on the medium with a previously sterilized bacteriological loop using sterile water. The plates were incubated for 24 hours at 37°C. After this procedure, each plate was analyzed by visual inspection.

Figure 2 A: LB, and B: BHI agar where the samples; PUFn, PUFb, PUFt, PUFr. The control sample, sterile water, and sterile loop, of interest were inoculated to verify the sterilization process.
After conducting the sterility test, the comparison between the PUFs continued to determine whether the treatment conditions of each PUF affected the recovery of microorganisms. For this, all four PUFs were exposed to the laboratory environment on a workbench for 24 hours. After this period, the corresponding tests were carried out following the previously described process. Two positive controls for microbial growth were used: a sample of non-sterilized common paper and tap water, where microbial growth is expected, and two negative controls: sterile water and a fragment of sterile PUFn, where microbial growth is not expected, incubating time and temperature were the same. Results were also analyzed by visual inspection.
The sterility test demonstrated that the PUFs were not contaminated and did not contain any microorganisms, as shown in Figure 3. Both plates displayed the same result, showing microbial growth in the control sample and PUFn, which were not sterilized. No growth was observed in the other quadrants: PUFb, PUFt, and PUFr, which were sterilized, as well as in the sterile water inoculation and the streak made with the sterile bacteriological loop, which also showed no microbial growth. This indicates that the sterilization of the PUFs was effective.
Figure 3 A: LB, B: BHI agar, where it can be observed that there was no microbial growth in PUFb, PUFt, and PUFr, but growth was observed in PUFn and the control sample.
This study determines whether PUFs are affected in their ability to recover microorganisms present in the environment after applying the cleaning and/or sampling procedures as indicated by the TO-13A method, with the aim of demonstrating whether PUFs can be reused. For this test, PUFt and PUFr were used to assess microorganism recovery, along with controls, PUFn and PUFb. This indicates that the cleaning treatment in the case of PUFt, and the extraction process in the case of PUFr, do not adversely affect the recovery of microorganisms from these PUFs (Figure 4).
The results demonstrate that the PUF can be reused after sample extraction, as the treatment and process applied to the PUF do not affect the recovery of microorganisms from the environment. However, a sterilization process is required before performing any test with them. Therefore, it is concluded that the PUF can be reused without compromising the results, as shown in Figure 4, and could help to minimize cost and waste after sampling.
GMHV and PMCB thank CONAHCYT for the postdoctoral scholarship CVU 263595 and 710042, respectively.
The experimental work was carried out with the financial support of the Consejo de Ciencia y Tecnología del Estado de Puebla (CONCYTEP).
The authors declare no conflict of interest in writing the manuscript.

©2024 Horta-Valerdi, et al. This is an open access article distributed under the terms of the, which permits unrestricted use, distribution, and build upon your work non-commercially.
 International Day for Biological Diversity, 2026 is observed every year on May 22nd
to emphasize the importance of protecting nature. The theme for 2026 is “Acting locally for global impact.” This day reminds
us of the need to protect nature, preserve species, and promote harmony with our planet. Together, we can safeguard biodiversity
for a sustainable future. On this occasion, MOJ Ecology & Environmental Sciences invites researchers to contribute articles in the
field of Ecology and Environ.
International Day for Biological Diversity, 2026 is observed every year on May 22nd
to emphasize the importance of protecting nature. The theme for 2026 is “Acting locally for global impact.” This day reminds
us of the need to protect nature, preserve species, and promote harmony with our planet. Together, we can safeguard biodiversity
for a sustainable future. On this occasion, MOJ Ecology & Environmental Sciences invites researchers to contribute articles in the
field of Ecology and Environ.